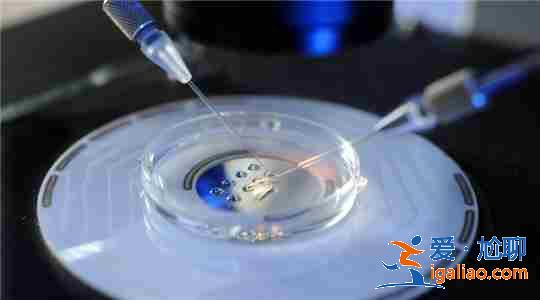
銀川代懷生子,貼心服務? 銀川代懷生子,貼心服務?

銀川代懷生子,貼心服務?
銀川代懷生子,貼心服務,AA69助孕對外提供延時助孕服務、預約AA69助孕服務、引領AA69助孕服務,AA69助孕服務指南、AA69助孕流程圖表、助孕收費指南等全部通過網絡對外公開公布。
在醫療技術不斷發展的今天,試管嬰兒技術已經發展的很成熟了,很多人通過試管嬰兒技術擺脫了不孕不育的困擾,因此很多不孕不育患者也想通過試管嬰兒技術實現“為人父母”夢想。
分享一些試管嬰兒常識:
打完hpv多久可以備孕
病情診斷:hpv疫苗接種完畢后,至少要在等半年才建議備孕。而且在半年后準備備孕之前也需要去醫院做相應的健康檢查,列如B超檢查,好清楚的知道子宮附件的情況;還需要去做婦科檢查,看是否患有炎癥;需要進行血液檢查,好了解內分泌的具體情況還有甲狀腺的功能,并還要進行白帶常規檢查等。通過這些檢查可以排除對懷孕不利的疾病。建議在打完后的一周內不可以喝酒、抽煙,在飲食上應該要去吃一些清淡營養的食物,在平時建議可以多喝牛奶,多吃魚類。
【實力保障】【預約咨詢】【全方位一站式助孕平臺】【擇優而生】【100%包成功】

試管助孕的流程解讀!全程需要這幾個步驟
試管嬰兒怎么放到肚子里?
1.前期準備和取卵
經歷前期的促卵泡發育治療,打過促排卵針后約36小時就可以取卵。取卵當天,女方取卵,男方取精。取卵過程:在超聲引導下,針頭會經陰道穿到卵巢內,將卵泡液和卵子吸出。取卵手術全程不到半小時,根據不同情況進行麻醉,并沒有傳說中那么痛苦。
取完卵后,最忙的時候到了,醫生們要把獲取的卵子和優化的精子放一起或直接精卵顯微注射,觀察是否受精,并進行胚胎培養等一連串關鍵性的步驟。
2.卵子收集
在恒溫熱臺上把混在卵泡血水中的卵子一顆顆找出來,洗滌,迅速轉移至培養皿,放入胚胎培養箱中。
男方在女方取卵當日完成取精,實驗室醫生等待精液標本液化后進行優化處理。
胚胎實驗室最重要的設備就是培養箱,一個個的培養箱相當于女性子宮,溫度保持在37℃,濕度、二氧化碳濃度等都參照人體相關指數調節。
3.體外受精
卵子收集后,加入一定數量的活動精子,稱為常規體外受精方式(俗稱第一代試管嬰兒),精卵在類似自然環境中完成受精過程。第二種授精方式為卵胞漿內單精子顯微注射受精(俗稱第二代試管嬰兒),就是用顯微注射針直接將精子穿刺注入卵細胞漿中,使卵子完成受精的技術,簡單的來說,顯微注射是一種人工干預的受精方式,只需幾個至幾十個精子就可以,這項技術為過去被視為不治之癥的男性患者帶來了希望。兩種受精方式分別適用于不同的人群,由臨床醫生根據適應癥進行把握。
4.檢查受精情況
取卵第二天清晨觀察受精情況,觀察到兩個原核視為正常受精,觀察到多個原核的受精卵(多精受精)予以廢棄。
5.胚胎觀察
取卵后3-5天觀察胚胎發育情況并進行評分。
體外培養的時間一般為三天,這時的胚胎一般發育到8細胞階段。如將胚胎繼續培養至第5-6天,即可發育到囊胚階段。做試管嬰兒時所說的囊胚培養,就是指這個時期的胚胎。
6.胚胎冷凍
移植后多余的胚胎怎么辦?一旦鮮胚周期胚胎種植失敗,冷凍的胚胎還可以解凍,做第二次移植,或者新鮮周期存在可能影響胚胎種植的因素,可以將全部胚胎進行冷凍,待子宮內膜準備好后進行凍胚移植。
胚胎儲存在一個個溫度處于零下196℃的液態罐中,每一個胚胎并不是孤孤單單一個人,而是和兩至三個“姐妹”們,一起待在一個冷凍載體里。通過特殊的技術,使原本接近人體體溫的37℃,下降到零下196℃的狀態,在液態罐里默默沉睡直至被喚醒,移植回母體子宮內。
7.胚胎移植
將準備好的胚胎通過一次性移植管植入母體子宮內的過程,胚胎移植術是無創性手術,不會疼痛,順利時10分鐘即可完成。術前需要憋尿,方便B超監視及保證胚胎移植術的順利進行。
試管嬰兒主要分為7個過程,試管嬰兒是一種無創的手術,不會疼痛。適用于輸卵管閉塞等問題的患者,當然備孕前檢查身體,能更好地應對備孕中出現的問題。
試問誰不想看著自己身邊兒女成群于膝下玩樂、打鬧、玩樂,可是對于不孕不育的患者來說,這卻是一個美麗卻可能實現不了的幸福畫面。但現在隨著試管嬰兒技術的發展普及,很多的不孕不育家庭也成功擁有了健康的小寶寶。對于不孕不育的家庭來說,試管嬰兒無異于是可以幫助她們解決沒有寶寶的煩惱。而在一系列做試管嬰兒的國家當中,泰國以其高性價比和高成功率成為了很多人的首選之地。但是如果你是目前有打算去泰國做試管嬰兒的,建議你看下以下內容,參照下列試管嬰兒的條件。
試管嬰兒需要的條件
1、雙側輸卵管堵塞、切除者;
2、雙側輸卵管發生嚴重黏膜損害、失去功能者;
3、子宮內膜異位癥:Ⅲ-Ⅳ期子宮內膜異位癥;
4、高齡伴卵巢儲備功能下降,備孕一年仍然不孕者;
5、反復人工授精失敗,或反復門診促排卵治療仍然不能懷孕者;
6、男方精液活力差或畸形精子多;7、婦科不孕癥手術:如輸卵管粘連分解手術、盆腔粘連分解手術、內膜異位癥手術,積極備孕半年到一年仍然不孕者。
試管嬰兒的費用一般可以分為以下幾部分。
試管嬰兒的價格是多少?
試管嬰兒是比較常見的一種輔助生殖技術,做試管嬰兒的費用在五萬元左右。由于各醫院的收費標準不同,試管嬰兒的具體費用也會不一樣,患者可以去正規的醫院進行試管嬰兒,注意加強營養攝入。
【17年行業經驗】【100%包成功】【可選男女】【定制套餐】【供精自懷】
分享一個真實案例:
祝賀山東C女士喜提1枚兒子,結束漫長的求子道路
山東陳女士備孕5年,不知道吃了多少苦,受了多少難,期間做了2次腹腔鏡,通了5次輸卵管,試管失敗4次,從30歲的年紀拖到了36歲。
陳女士不想放棄,也不想浪費時間,聽說有第三方輔助生殖這條路可以走,她想試一試,就算傾家蕩產也要實現生兒育女的心愿。于是和老公一起在網上做了不少功課,因為身邊沒有人打過頭陣,所以兩人非常費心,一家一家走訪<愛尬聊_健康養生>考察。
經過半年時間的考慮,最終決定在【呂進峰輔助生殖機構】操作,和客戶經理見過2次面后就簽訂了合同,因卵泡只有十個,選擇做二代試管。
整個過程進展的非常順利,取到的10個卵子配了5個胚胎,2A1B2D,2次移植機會。
在大家的齊心協力下,一次移植就成功了,志愿者和寶寶相處的很愉快,生產當日兩人也都平平安安,陳女士夫婦也收獲了人生第一個baby,還是個兒子哦~
【專家團隊】【無需三證】【高齡求子】【權威醫療合作】【全方位一站式助孕平臺】

全面介紹母嬰小知識
在懷孕前期,孕婦去醫院做第一次產檢時,醫生就會幫助計算預產期,預產期是一個預計會生產的日期,超過預產期肚子還沒動靜時,就會比較著急,想要去檢查,那么預產期過了要做什么檢查?
一般自身身體健康,胎兒也沒有異常時,建議選擇自然分娩,自然分娩時胎兒要通過產道,經過產道擠壓,呼吸功能更健全,同時對子宮傷害較小。剖腹產不僅會傷害皮膚組織,還會傷害子宮,大大的損失孕婦元氣,后期恢復慢,會在皮膚上面留下傷疤,影響整體美觀。
關于《銀川代懷生子,貼心服務》就簡單介紹到這里!
